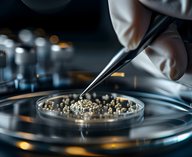
платина, катализатор, химия, производство, промышленность

Японский стартап SkyDrive провел первый демонстрационный полет своего «летающего автомобиля» в Токио. Компания рассчитывает запустить коммерческие рейсы в отдельных регионах Японии в 2028 году.
Во время испытаний беспилотный аппарат под дистанционным управлением пролетел над Токийским заливом около трех с половиной минут. За это время он преодолел расстояние в 150 метров.
Электрическая модель SD-05 получила 12 двигателей и три посадочных места. Аппарат пролетает от 15 до 40 километров. Благодаря компактности и малому весу машина приземляется на площадках, которые не подходят для обычных вертолетов.
Разработчики также представили специальный терминал. В нем операторы контролируют взлеты и посадки, а пассажиры проходят автоматическую регистрацию по лицу и проверку безопасности.
Глава SkyDrive Томохиро Фукудзава ожидает, что после 2030 года стоимость полета упадет до уровня двух поездок на такси. Он уверен, что новинка быстро станет популярной, так как машина перемещается в пять раз быстрее наземного транспорта и экономит время.